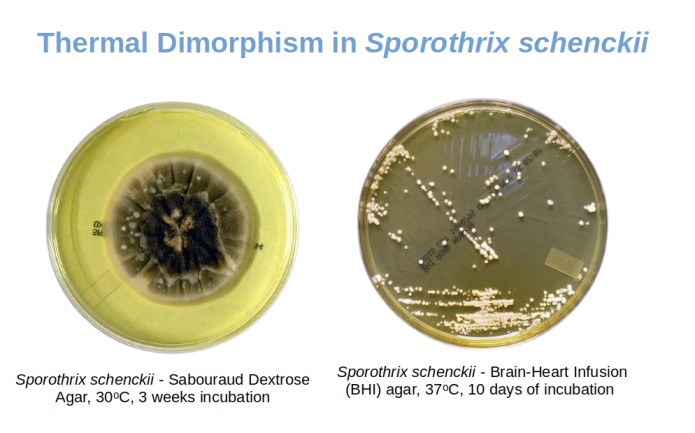
- Sporothrix schenckiigives mold colonies at environmental temperature and yeast-like colonies are 37°C(Imagesource)

Fungi can be broadly classified into two groups; yeasts and molds. Yeasts are single-celled organisms that reproduce by budding, but molds grow as filament-like structures and reproduce primarily using asexual reproductive spores such as conidiospores, sporangiospores, and arthrospores.
Properties
Dimorphic fungi exist as molds in the environment at ambient temperature (25°C– 30°C) and as yeasts (or other structures, e.g., spherules in case of Coccidioides immitis) in human tissues at body temperature (35°C -37°C). Many medically important fungi show this unique behavior based on the temperature of growth and habitat.
Mnemonic:Mold in theCold,Yeast in theHeat (Beast)
Most dimorphic fungi cause systemic mycoses and Sporothrix (one of the dimorphic fungi) causes subcutaneous mycoses.
Note: All molds should be handled within appropriate biological safety cabinets to avoid a laboratory-acquired infection.
Disease caused byDimorphic Fungi
| Name of dimorphic fungi | Disease | Important clinical findings |
|---|---|---|
| Histoplasma capsulatum | Histoplasmosis | Cavitary lung lesions, granulomas in liver and spleen |
| Blastomyces dermatitidis | Blastomycosis | Ulcerated lesions of the skin |
| Paracoccidioides brasiliensis | Paracoccidioidomycosis | Ulcerated lesions of the face and mouth |
| Coccidioides immitis | Coccidioidomycosis | Valley fever in immunocompetent; dissemination to meninges in immunocompromised |
| Sporothrix schenckii | Sporotrichosis is “rose gardener’s disease.” | Local abscess or ulcer with nodules in draining lymphatics |
| Talaromyces marneffei | Talaromycosis | Tuberculosis-like disease in AIDS patients |
Examples of Dimorphic Fungi
Inhalation of spores of these dimorphic fungi causes systemic mycoses;

Histoplasma capsulatum
H. capsulatum is a dimorphic fungus that exists as a mold in soil and as yeast in tissue. It causes histoplasmosis. (Note: It does not possess a capsule)
Blastomyces dermatitidis
B. dermatitidis is a dimorphic fungus that exists as a mold in soil and spherule in tissue. The yeast has a characteristic double refractive wall and a single broad-based bud.
Paracoccidioides brasiliensis
P. brasiliensis is a dimorphic fungus that exists as a mold in soil and yeasts in tissue. The yeast is thick-walled and has multiple buds. It causes Paracoccidioidomycosis, formerly named “South American blastomycosis,”.
Coccidioides immitis
It is a dimorphic fungus that exists as a mold in soil and yeast in tissue. It causes coccidioidomycosis.
Sporothrix schenckii
Sporothrix schenckiiis a notable dimorphic fungus; it causes subcutaneous mycoses named sporotrichosis.
Talaromyces marneffei
Talaromyces marneffei, formerly Penicillium marneffei, is a mold in environmental conditions, and yeast form is seen in tissues. It is an opportunistic pathogen causing systemic penicilliosis in AIDS patients in Thailand, China, Hong Kong, Vietnam, and other parts of Southeast Asia.

Mnemonicsto Remember Dimorphic Fungi
- Mold in the Cold,Yeast in the Heat (Beast)
- Body Heat Probably Changes ShaPe of the dimorphic fungi
Blastomyces Histoplasma Paracoccidioides Coccidioides Sporothrix Penicillium marneffei(Talaromyces marneffei)
Note: Candidaand Cryptococcusare not dimorphic fungi; they are true yeast.
Cryptococcus neoformansis an encapsulated, unicellular (yeast). It can cause pneumonia and cryptococcal meningitis in immunocompromised patients.
Candida is a yeast; it can cause candidiasis “thrush.” In immunocompromised individuals, invasive candidiasis may develop.
Colony Morphology of Dimorphic Fungi
- If the organism is dimorphic fungi, you may observe mixtures of yeast and mold forms. In slow-growing dimorphic fungi, mold appears hair-like or cobweb-like consistency. The mold form can be converted to yeast by incubating subcultures on enriched media at 37°C.
- During a mold-to-yeast conversion of Blastomyces dermatitidis, an intermediate form known as the “prickly stage” can be seen. A microscopic preparation of such stage may show a mixture of hyphae, budding yeasts, and forms intermediate between the two.
- Yeast forms of dimorphic fungi are similar to other true yeasts. In contrast to yeasts, they are generally slow-growing, and the colonies remain quite small.
References
- Klein, B. S., & Tebbets, B. (2007). Dimorphism and virulence in fungi. Current opinion in microbiology, 10(4), 314–319. https://doi.org/10.1016/j.mib.2007.04.002
- Rappleye, C. A., & Goldman, W. E. (2006). Defining virulence genes in the dimorphic fungi. Annual review of microbiology, 60, 281–303. https://doi.org/10.1146/annurev.micro.59.030804.121055
- Bemmann W. (1981). Pilzdimorphismus – eine Literturübersicht [Dimorphism of fungi – review of the literature]. Zentralblatt fur Bakteriologie, Parasitenkunde, Infektionskrankheiten und Hygiene. Zweite naturwissenschaftliche Abteilung: Mikrobiologie der Landwirtschaft der Technologie und des Umweltschutzes, 136(5), 369–416.